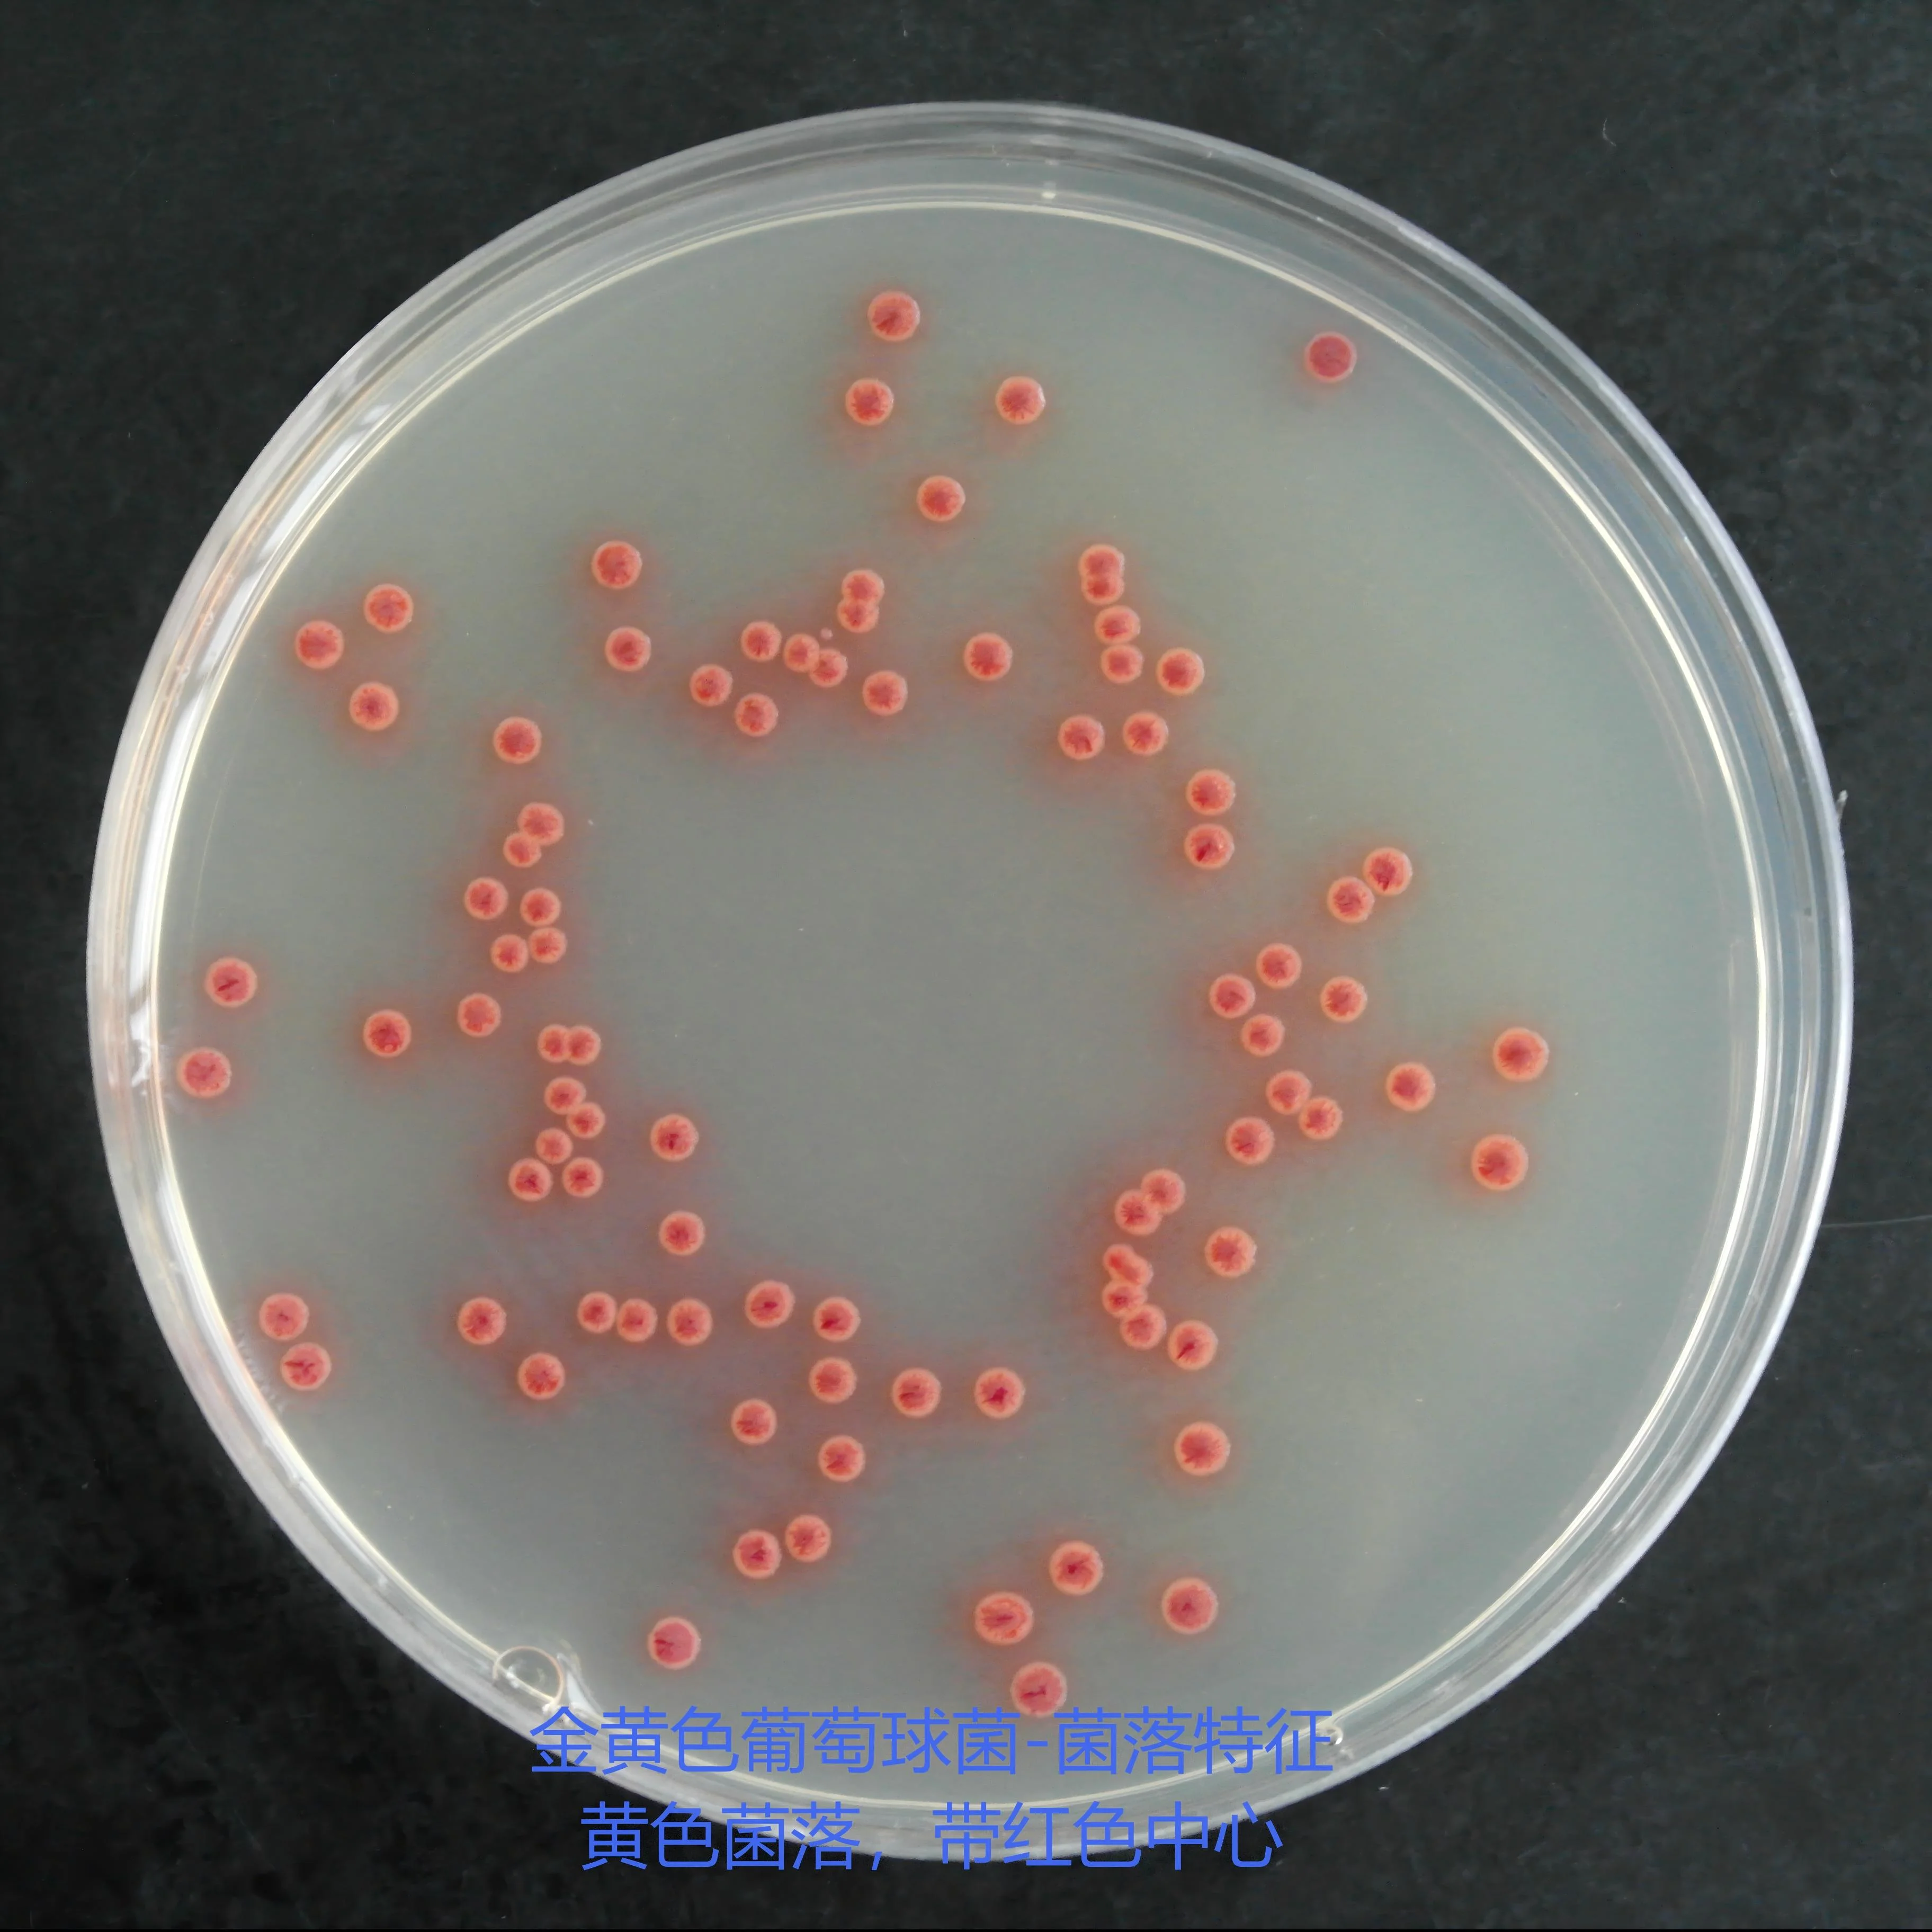
金黄色葡萄球菌-菌落特征：黄色菌落，带红色中心

商品详细
说明书
微生物图册
行业应用
相关论文
产品名称:TTC营养琼脂
英文名称:TTC Nutrient Agar
产品编号与包装规格:
| 产品编号 | 产品类型 | 包装规格 |
|---|---|---|
| 022030 | 干粉 | 250g/瓶 |
产品用途:供测定细菌总数用,本品能防止菌落蔓延,使菌落变红易计数。
检验原理:蛋白胨和牛肉膏粉提供氮源、维生素、氨基酸和碳源;氯化钠能维持均衡的渗透压;琼脂是培养基的凝固剂;大多数细菌能还原TTC,使之形成易于辨别的红色菌落,TTC还能减缓某些细菌的蔓延生长。
TTC营养琼脂培养基配方成分:
| 配方(每升) | 含量 |
|---|---|
| 胨 | 10.0g |
| 牛肉膏粉 | 3.0g |
| 氯化钠 | 5.0g |
| TTC | 0.01g |
| 琼脂 | 15.0g |
| 最终pH 7.3±0.2 | |
使用方法:称取本品33g,加入蒸馏水或去离子水1 L,搅拌加热煮沸至完全溶解,分装三角瓶,121℃高压灭菌15min,备用。
TTC营养琼脂培养基质量控制(下列质控菌株接种待测试培养基,35~37℃,48±2hh结果如下:):
| 指标 | 质控菌株及编号 | 生长率 | 特征性反应 |
|---|---|---|---|
| 生长率 | 大肠埃希氏菌ATCC25922 | PR≥0.7 | 灰白色菌落,带红色中心 |
| 金黄色葡萄球菌ATCC6538 | PR≥0.7 | 黄色菌落,带红色中心 |
储存条件与保质期:贮存于避光、干燥处,用后立即旋紧瓶盖;保质期三年。
022030 TTC营养琼脂培养基 250g/瓶【干粉型】 相关产品(用于细菌总数测定及增菌培养):
| 产品名称 | 产品货号 | 规格 | 产品说明及用途 |
| 哥伦比亚琼脂培养基 Columbia Agar | 024061 | 250g | 加或不加脱纤维羊血或免血,用于营养要求较高的细菌培养及溶血试验,或用于梭菌检验(GB) |
| 锰盐营养琼脂 Manganese Nutrient Agar | 027120 | 250g | 用于嗜温或嗜热的需氧或厌氧芽孢杆菌的检测和培养(GB) |
| 脑心浸液琼脂培养基 (脑-心浸萃琼脂培养基) Brain Heart Infusion Agar | 028361 | 250g | 广泛用于霉菌、酵母、细菌的培养,包括营养要求较高的微生物培养,特别用于饮用矿泉水和城市供水中粪链球菌滤膜法的确证实验(GB) |
| SCDLP液体培养基 Soya Casein Digest Lecithin Polysorbate Broth | 027010 | 250g | 用于疏水性化妆品样品处理及化妆品和一次性使用卫生用品中细菌的增菌培养(GB、ISO) |
| 改良卵磷脂肉汤 Modified Letheen Broth | 027012 | 250g | 用于化妆品微生物检验中样品稀释和增菌(美国FDA、ISO) |
| 改良卵磷脂琼脂 Modified Letheen Agar | 027023 | 250g | 用于化妆品微生物检验中样品稀释和增菌(美国FDA、 ISO) |
| 卵磷脂-吐温80营养琼脂 (TTC卵磷脂-吐温80营养琼脂基础) Lecithin Tween-80 Nutrient Agar(TTC Lecithin Tween-80 Nutrient Agar Base) | 027020 | 250g | 用于化妆品细菌总数测定,临用前可加入TTC,制成TTC卵磷脂-吐温80营养琼脂,使菌落成红色(GB, 化妆品卫生规范2015) |
| LB肉汤(含糖) LB Broth(with sugar) | 028320 | 250g | 用于一般细菌培养,特别用于分子生物学试验中大肠杆菌的保存和增菌 |
| LB肉汤(不含糖) LB Broth(no sugar) | 028324 | 250g | 用于分子生物学中大肠杆菌的培养(美国FDA,lennox) |
| LB琼脂(不含糖) LB Agar(no sugar) | 028334 | 250g | 用于分子生物学中大肠杆菌的培养(美国FDA,lennox) |
| 氨苄青霉素LB琼脂 LB Agar with Ampicillin | 028335 | 250g | 用于分离含有抗氨苄青霉素质粒的大肠杆菌 |
| pH7.0氯化钠-蛋白胨缓冲液 Buffer Sodium Chloride | 022116 | 500g | 用于药品、生物制品的样品稀释(2020版CP、USP、EP) |
| 胰酪大豆胨液体培养基(TSB) Tryptic Soy Broth | 024048 | 250g | 用于药品及生物制品的无菌检查以及需氧菌MPN法计数(2020版CP、USP、EP) |
| 胰酪大豆胨液体培养基(TSB) Trypticase Soy Broth | 024048T1 | 10kg | 用于药品及生物制品的无菌检查以及需氧菌MPN法计数(2020版CP、USP、EP) |
| 硫乙醇酸盐流体培养基(FT)(药典) Fluid Thioglycollate Medium | 028033 | 250g | 用于培养需氧菌、微需氧菌和厌氧菌,还用于药品生物制品的无菌试验(2020版CP、USP、EP) |
| 硫乙醇酸盐流体培养基(高透明度) Thioglycollate Medium(Excellent Clarity) | 028034 | 250g | 用于培养需氧菌、微需氧菌和厌氧菌,还用于药品生物制品的无菌试验(2020版CP、USP、EP) |
| 胰酪大豆胨琼脂培养基 (大豆酪蛋白琼脂培养基)(TSA) Soybean Casein Digest Agar (Tryptic Soy Agar) | 028074 | 250g | 用于一般细菌培养,需氧菌总数计数及环境监测(2020版CP、USP、EP、GB) |
| R2A琼脂培养基 R2A Agar | 022029 | 250g | 用于水中细菌总数的测定(2020版CP、 USP、EP) |
| 0.5%葡萄糖肉汤培养基 0.5% Dextrose Broth | 028032 | 250g | 用于硫酸链霉素等抗生素的无菌检查及消毒技术规范(GB) |
| 平板计数琼脂(含糖琼脂PCA) Plate Counts Agar | 022070 | 250g | 用于细菌总数的测定(GB、SN、美国FDA、ISO) |
| 营养琼脂(NA)培养基(药典) Nutrient Agar Ⅱ | 022021 | 250g | 供细菌总数测定、保存菌种及纯培养用(CP) |
| 营养肉汤培养基(药典) Nutrient Broth Ⅱ | 022011 | 250g | 用于一般细菌培养、转种、复壮、增菌等(CP) |
| 0.1%蛋白胨水 0.1% Peptone Water | 028026 | 250g | 用于样品的稀释(CP) |
| 磷酸盐缓冲液(PBS) Peptone Buffered Solution | 022117 | 250g | 用于样品的稀释(CP) |
| 蛋白胨-盐溶液 Peptone Salt Solution | 027405 | 250g | 用于乳与乳制品中嗜冷菌测定样品的稀释(NY/T1331-2007) |
| 营养肉汤(NB)培养基 Nutrient Broth | 022010 | 250g | 一般细菌培养、转种、复壮、增菌等,也可用于消毒效果测定(GB) |
| 营养琼脂(NA)培养基 Nutrient Agar | 022020 | 10kg | 供细菌总数测定、保存菌种及纯培养用,也可用于消毒效果测定(GB、 ISO) |
| LG培养基 LG Medium | 021140B | 10kg | 用于霉菌、酵母菌、耐热霉菌及细菌总数的检测,可用于 PET瓶及无菌罐装生产线的无菌测试 |
| M-TGE肉汤 mTGE Broth | 022075 | 250g | 用于滤膜法细菌总数计数 |
| 橙血清琼脂 Orange Serum Agar | 027400 | 250g | 用于培养耐酸的微生物,特别是柑橘产品的微生物 |
| 液体硫乙醇酸盐培养基(FT) Fluid Thioglycollate Medium | 028030 | 250g | 用于培养需氧菌、微需氧菌和厌氧菌,及食品中产气荚膜梭菌的厌氧培养(美国FDA、GB、SN) |
| 胰蛋白胨大豆肉汤(TSB) Trypticase(Tryptic) Soy Broth (Soybean Casein Digest Broth) | 024051 | 250g | 用于广泛微生物培养,尤其是金黄色葡萄球菌、溶血性链球菌、蜡样芽孢杆菌检验(GB、美国FDA) |
| 脑心浸出液肉汤(BHI) Brain Heart Infusion Broth | 024053 | 250g | 用于金黄色葡萄球菌的培养,还可用于霉菌、酵母、细菌的培养,包括营养要求较高的微生物的培养(GB、 美国FDA、ISO) |
| 溴甲酚紫葡萄糖蛋白胨水培养基 BCP Dextrose Peptone Medium | 028073 | 250g | 用于压力蒸汽灭菌效果评价(GB) |
| 酸性肉汤 Acid Broth | 027110 | 250g | 用于酸性罐头食品商业无菌检验(GB、美国FDA) |
| 溴甲酚紫葡萄糖肉汤 Bromcresol Purple Dextrose Broth | 027100 | 250g | 用于培养细菌和鉴别细菌发酵葡萄糖试验,还用于低酸性罐头食品商业无菌检验(GB、美国FDA) |
